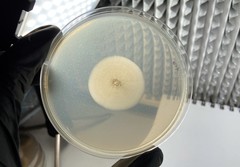
Geotrichum
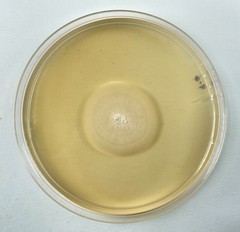
Geotrichum

Geotrichum: taxon details and analytics
- Domain
- Kingdom
- Fungi
- Phylum
- Ascomycota
- Class
- Saccharomycetes
- Order
- Saccharomycetales
- Family
- Dipodascaceae
- Genus
- Geotrichum
- Species
- Scientific Name
- Geotrichum
Summary description from Wikipedia:
Geotrichum
Geotrichum is a genus of fungi found worldwide in soil, water, air, and sewage, as well as in plants, cereals, and dairy products; it is also commonly found in normal human flora and is isolated from sputum and feces. It was first described in 1809 by Johann Heinrich Friedrich Link.
The genus Geotrichum includes over 100 species. Some are welcome and even considered desirable. For example, skilled cheesemakers create conditions favorable for the formation of a Geotrichum candidum rind on certain goat's milk and cow's milk cheeses, proudly declaring the rind to be the most flavorful part of such cheeses. Another example is the presence of some Geotrichum species in fermented poi.
The most clinically relevant species is Saprochaeta capitata, formerly known as Geotrichum capitatum, with most cases occurring in Europe.
Saprochaete clavata, formerly known as Geotrichum clavatum, is an uncommon infection that has been associated with sporadic outbreaks. Geotrichum candidum is closely related to Saprochaeta sp., rarely isolated but may cause invasive and disseminated disease with high mortality yeast-like and mold-like strains have been identified.
The most important risk factor for invasive fungal infection related to Geotrichum is severe immunosuppression, especially in hematological malignancies as acute leukemia, associated with profound and prolonged neutropenia.
Fungemia is very common, often with deep organ involvement (lung, liver, spleen, and central nervous system) and also skin and mucous membranes lesions. There is no optimal treatment for Geotrichum infections but based on existing data guidelines recommend amphotericin B with or without co-administered flucytosine or with voriconazole showing good in vitro susceptibility.
Mortality associated with Geotrichum-related infections is high, ranging from 57% to 80%.
Increasing the knowledge on Geotrichum related invasive fungal infections may improve early diagnosis and adequate treatment of these severe infections.
...